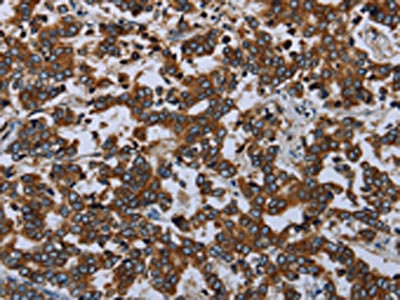

AVEN Antibody
-
中文名稱:AVEN兔多克隆抗體
-
貨號:CSB-PA403881
-
規(guī)格:¥1100
-
圖片:
-
The image on the left is immunohistochemistry of paraffin-embedded Human liver cancer tissue using CSB-PA403881(AVEN Antibody) at dilution 1/20, on the right is treated with synthetic peptide. (Original magnification: ×200)
-
The image on the left is immunohistochemistry of paraffin-embedded Human colon cancer tissue using CSB-PA403881(AVEN Antibody) at dilution 1/20, on the right is treated with synthetic peptide. (Original magnification: ×200)
-
-
其他:
產(chǎn)品詳情
-
Uniprot No.:
-
基因名:AVEN
-
別名:1700013A01Rik antibody; 1700056A21Rik antibody; Apoptosis caspase activation inhibitor antibody; AVEN antibody; AVEN_HUMAN antibody; Cell death regulator Aven antibody; mAven L antibody; mAven S antibody; MGC124011 antibody; OTTMUSP00000016129 antibody; PDCD12 antibody; Programmed cell death 12 antibody; RP23-52C15.2 antibody
-
宿主:Rabbit
-
反應種屬:Human,Mouse
-
免疫原:Synthetic peptide of Human AVEN
-
免疫原種屬:Homo sapiens (Human)
-
標記方式:Non-conjugated
-
抗體亞型:IgG
-
純化方式:Antigen affinity purification
-
濃度:It differs from different batches. Please contact us to confirm it.
-
保存緩沖液:-20°C, pH7.4 PBS, 0.05% NaN3, 40% Glycerol
-
產(chǎn)品提供形式:Liquid
-
應用范圍:ELISA,IHC
-
推薦稀釋比:
Application Recommended Dilution ELISA 1:1000-1:2000 IHC 1:25-1:100 -
Protocols:
-
儲存條件:Upon receipt, store at -20°C or -80°C. Avoid repeated freeze.
-
貨期:Basically, we can dispatch the products out in 1-3 working days after receiving your orders. Delivery time maybe differs from different purchasing way or location, please kindly consult your local distributors for specific delivery time.
-
用途:For Research Use Only. Not for use in diagnostic or therapeutic procedures.
相關產(chǎn)品
靶點詳情
-
功能:Protects against apoptosis mediated by Apaf-1.
-
基因功能參考文獻:
- AVEN and BIRC6 are inhibited by combination therapy of miR-30e and proanthocyanidin in glioblastoma stem cells PMID: 27388765
- The Aven RGG/RG motif bound G4 structures within the coding regions of the MLL1 and MLL4 mRNAs increasing their polysomal association and translation, resulting in the induction of transcription of leukemic genes. PMID: 26267306
- the expression of Aven is regulated by the Akt signaling pathway through cathepsin D activity, which contributes to the sensitivity of cancer cells to chemotherapeutic agents. PMID: 25573060
- The findings implicate Aven in ATR-Chk1 signalling and point towards Chk1 inhibition as a strategy to sensitize human osteosarcomas to chemotherapy. PMID: 25757065
- Overexpression of the anti-apoptotic protein AVEN contributes to increased malignancy in hematopoietic neoplasms. PMID: 22751129
- a model of Aven activation by which its N-terminal inhibitory domain is removed by CathD-mediated proteolysis, thereby unleashing its cytoprotective function. PMID: 22388353
- The results suggest that deregulation of the expression of the apoptosis inhibitor Aven may be related to male factor infertility. PMID: 21718987
- the expression level of aven mRNA in de novo AML patients obviously increases PMID: 20030919
- Results suggest that the regulation of Exportin-1/CRM1-dependent nucleocytoplasmatic traffic of Aven could modulate its ability to influence cell cycle progression. PMID: 20935510
- Aven expression was found to be higher in patients >or=10 years old or <1 year, and with unfavorable cytogenetic abnormalities. It was also significantly higher in relapsed patients in the standard-risk group and an independent poor prognostic factor. PMID: 16388850
- point mutation observed by transcriptome sequencing of malignant pleural mesothelioma tumors PMID: 18303113
- These results identify Aven as a new ATM activator and describe a positive feedback loop operating between Aven and ATM; in aggregate, these findings place Aven, a known apoptotic inhibitor, as a critical transducer of the DNA-damage signal. PMID: 18571408
顯示更多
收起更多
-
亞細胞定位:Endomembrane system; Peripheral membrane protein. Note=Associated with intracellular membranes.
-
組織特異性:Highly expressed in testis, ovary, thymus, prostate, spleen, small intestine, colon, heart, skeletal muscle, liver, kidney and pancreas.
-
數(shù)據(jù)庫鏈接:
Most popular with customers
-
-
YWHAB Recombinant Monoclonal Antibody
Applications: ELISA, WB, IHC, IF, FC
Species Reactivity: Human, Mouse, Rat
-
Phospho-YAP1 (S127) Recombinant Monoclonal Antibody
Applications: ELISA, WB, IHC
Species Reactivity: Human
-
-
-
-
-